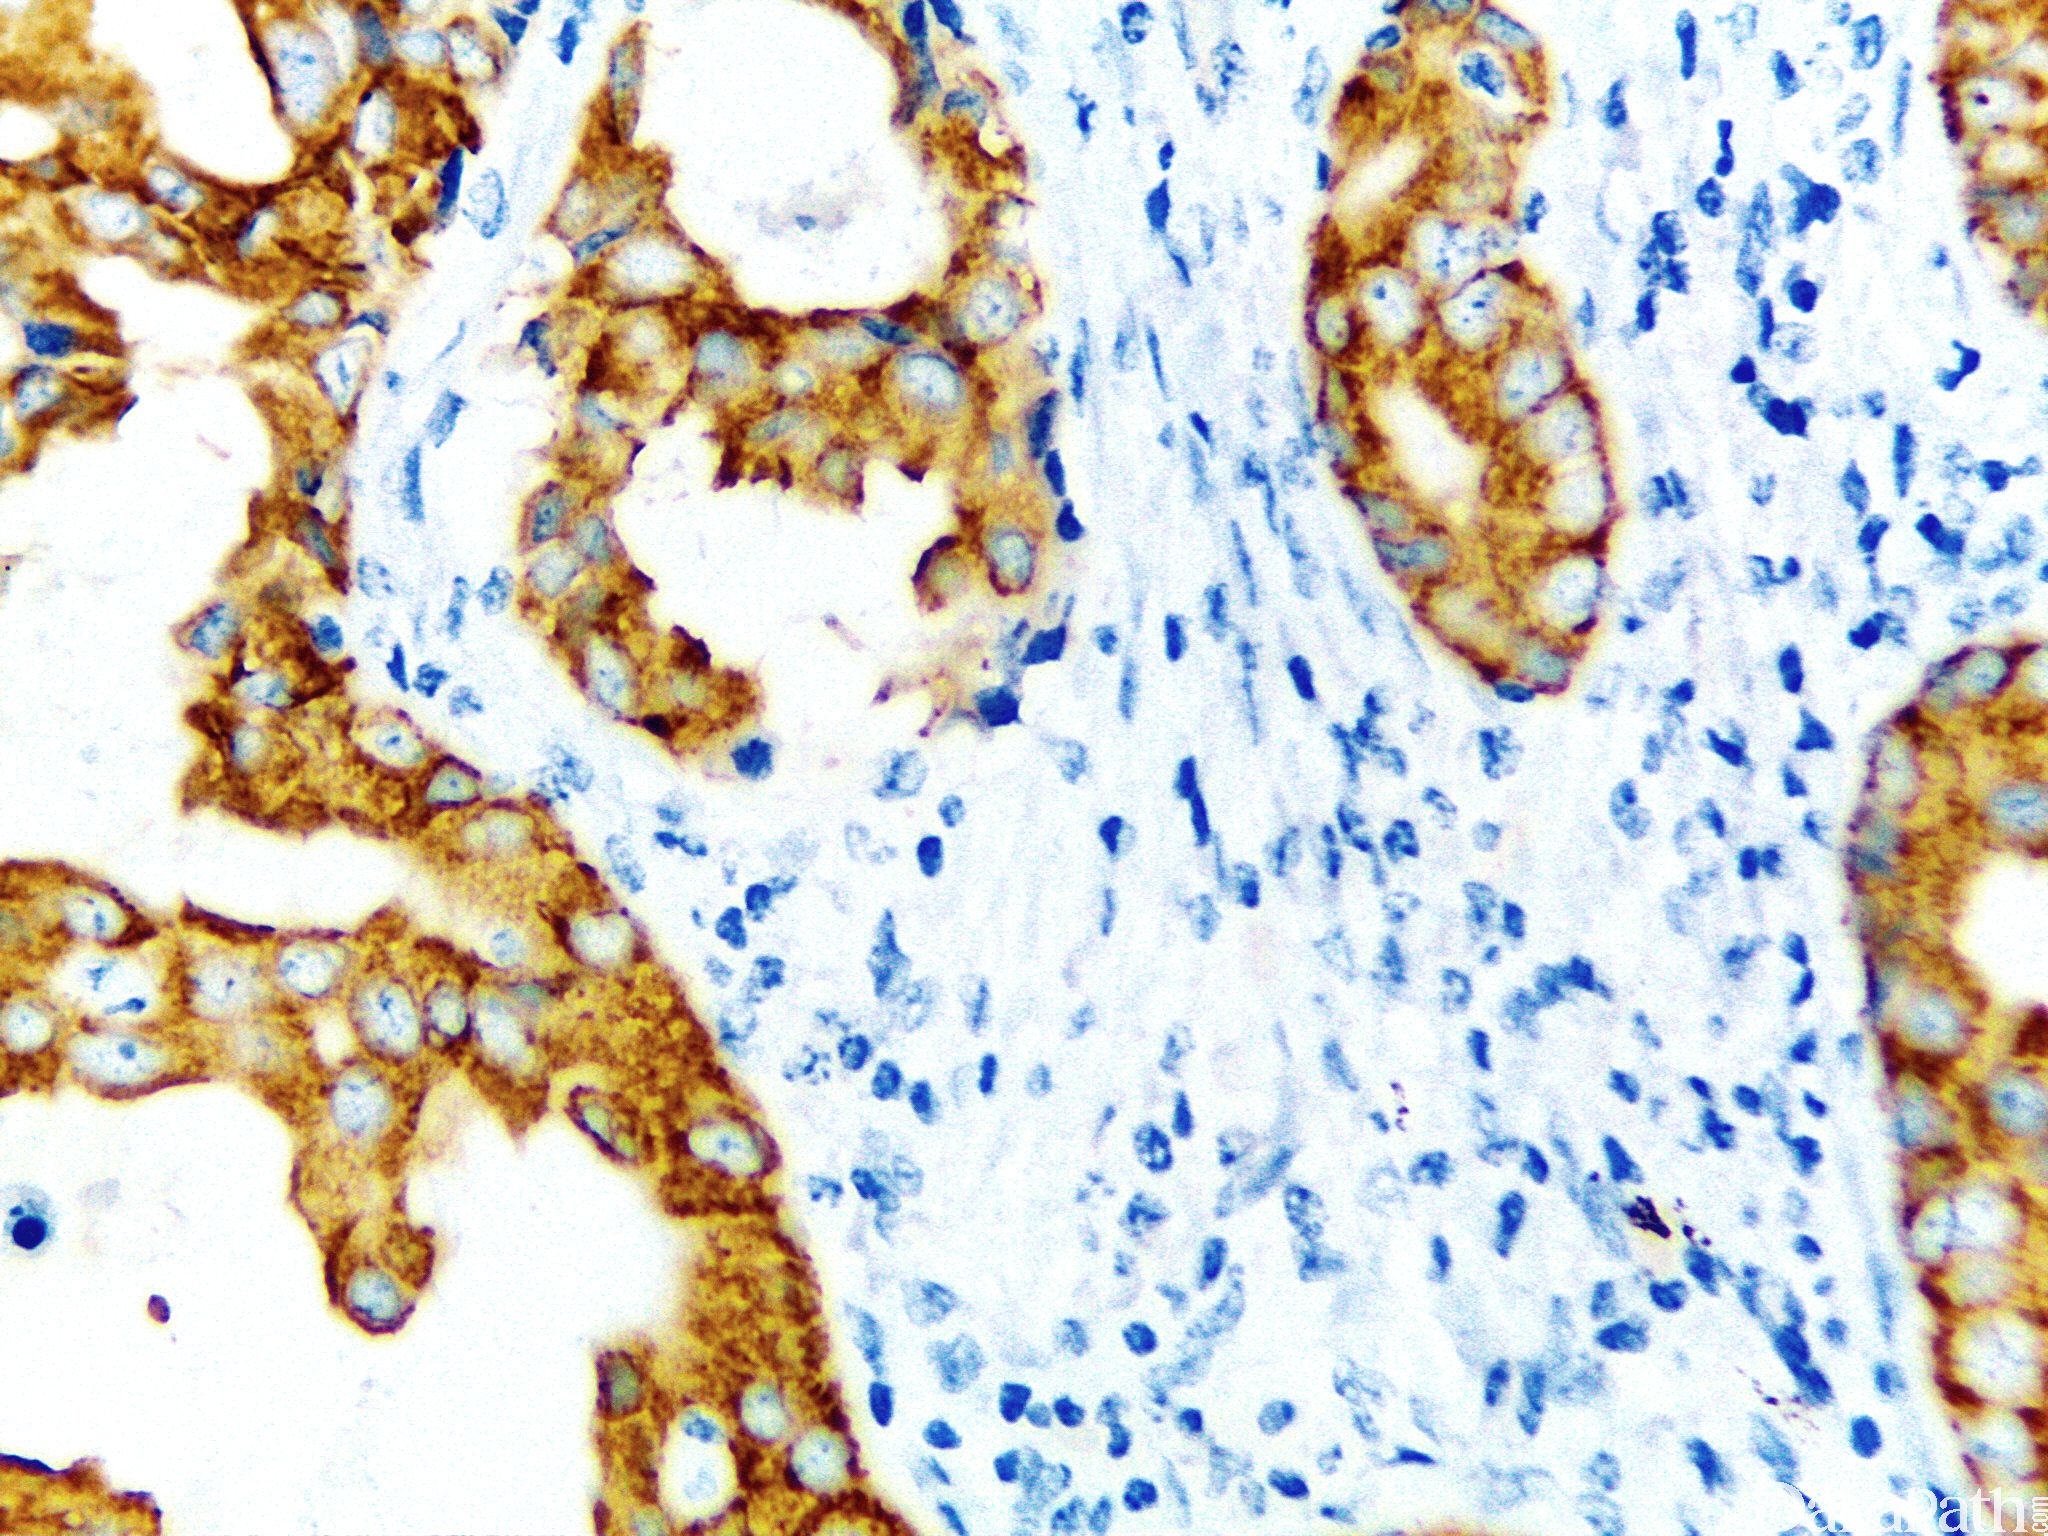

IMP3

别名: BRMS2, C15orf12, FLJ10968, MRPS4
概述:
IMP3 是一种致癌胎儿蛋白,属于胰岛素样生长因子 II mRNA 结合蛋白(IMP)。在成人组织中,IMP3 低表达或不表达,但在恶性肿瘤中,如在胃、结肠、胰腺、肺、肾细胞和肝癌中存在过表达。
信号定位: 胞浆
在病理学中的应用:
1、胰腺癌比较敏感的标记;
2、辅助子宫浆液性癌和子宫内膜样腺癌的鉴别诊断。
商品化试剂(排名不分先后,本网站对抗体质量不负责!)
公司 | 克隆号 | 即用型(ml) | 原液(ml) | ||||
赛诺特 | EP286 | 1 | 3 | 6 | / | 0.1 | 0.2 |
中杉金桥 | EP286 | 1.5 | 3 | 6 | / | 0.1 | 0.2 |
安必平 | 69.1 | 1.5 | 3 | 6 | / | 0.1 | 0.2 |
福建迈新 | EP286 | 1.5 | 3 | 6 | / | / | 0.2 |
